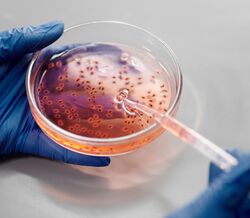

Porque as mulheres são o sexo mais forte
As mulheres sobrevivem à exaustão, à fome e até ao coronavírus melhor do que os homens. Porquê? Por serem genericamente mais fortes. Descubra o que um cientista especializado em genética, detentor de respostas revolucionárias, tem a dizer-nos sobre esta mudança de paradigma.

O coronavírus está a matar mais homens do que mulheres. Nas primeiras seis semanas [da pandemia], um número quase idêntico de homens e de mulheres foi infetado com a doença, mas só 1,7% das mulheres morreram em comparação com 2,8% dos homens. Os cientistas acham que sabem porquê. Os sistemas imunitários das mulheres são mais fortes do que os dos homens. Foram construídos dessa forma. O Dr. Sharon Moalem, um médico nascido no Canadá, especialista em doenças raras e autor de livros científicos, defende a teoria segundo a qual as mulheres são geneticamente mais fortes do que os homens. Em 2016, Moalem e a mulher, Anna, estavam a viajar de carro, em Toronto. Um outro carro atravessou um sinal vermelho e embateu no deles. "Capotámos", recorda.
"A cabina e o tejadilho abateram totalmente. Tivemos muita sorte em sobreviver. Se não nos tivéssemos baixado teríamos, provavelmente, sido decapitados. Estivemos mais de um mês hospitalizados com ferimentos muito parecidos." E é aqui que surge a coisa estranha: Anna teve alta duas semanas antes de Sharon. "O que foi mesmo percetível foi o tempo de regeneração", afirma-nos este cientista. "Nos cortes superficiais, por exemplo, o tempo de regeneração dela foi mais rápido. Tive mais infeções do que ela, as minhas infeções não se resolveram tão depressa e eu não recuperei da mesma maneira."

A demora da sua recuperação e a resiliência da sua mulher não o surpreenderam. Para ele, aquilo foi mais uma prova de que as mulheres são geneticamente superiores aos homens. Depois do acidente, Sharon Moalem decidiu escrever um livro sobre o assunto: The Better Half - On the Genetic Superiority of Women (Allen Lane, abril de 2020). As provas são concretas. As mulheres vivem, em média, mais do que os homens. Nascem mais homens do que mulheres – 105 para cada 100 – mas, chegados aos 40 anos, os números são iguais e, chegados aos 100, 80% dos sobreviventes são mulheres.
As mulheres sofrem menos defeitos congénitos do que os homens, como anquiloglossia [língua presa, uma anomalia rara] ou sindactilia [fusão parcial ou completa de dois ou de mais dedos da mão ou do pé], entre outros. Os homens têm 20% mais probabilidades de desenvolver cancro do que as mulheres e 40% mais probabilidades de morrer devido à doença. As crianças do sexo masculino têm o dobro das probabilidades de sofrer de problemas de desenvolvimento como síndrome de défice de atenção e hiperatividade, dificuldades de aprendizagem e disfemia [vulgo gaguês]. As mulheres costumam ter melhor visão a cores do que os homens e algumas são tetracromáticas [em suma, a capacidade de ver mais cores], o que significa que podem distinguir até 100 milhões de cores, não o milhão que a maioria dos homens tem dificuldade em identificar.
"Ah!", dirá a leitora, mas os homens têm mais força física do que as mulheres. Bem, não em termos de sobrevivência. Quando as políticas de Estaline, na Ucrânia soviética, forçaram milhões de pessoas a passar fome, sobreviveram mais mulheres do que homens. É verdade que os homens têm mais massa muscular e são melhores do que as mulheres na maioria dos desportos que exigem força. Nenhuma corredora de velocidade vai vencer Usain Bolt e os homens ainda dominam as maratonas. No entanto, os homens não são tão bons no que diz respeito a competições de resistência extrema, como as ultramaratonas. "Quanto mais longa for a corrida, mais difíceis são as condições e é então que os homens começam a desistir", esclarece Moalem. Esta questão ficou muitíssimo clara, no ano passado, quando Jasmin Paris, veterinária e mãe de 35 anos, venceu a corrida Montane Spine Race, de 430 quilómetros, ao longo do Pennine Way até à Escócia. "Jasmin quebrou o recorde do trilho em 12 horas.

Nos locais de repouso existentes ao longo do trilho, ela bombeava leite para a sua filha, enquanto os homens estavam de rastos, no chão." Moalem também menciona a corrida de ciclismo Transcontinental, uma corrida de bicicleta com cerca de quatro mil quilómetros pela Europa. No ano passado, essa prova também foi vencida por uma mulher, Fiona Kolbinger, uma aluna alemã de medicina de 24 anos. Isto está a acontecer porque as mulheres estão, cada vez mais, a participar em eventos que em tempos se consideraram demasiado difíceis para elas.
Na verdade, são mais fáceis para as mulheres do que para os homens. Porquê? "Nós consideramos que existem duas razões para isso", afirma Moalem. "Uma delas deve-se ao facto de as mulheres terem uma taxa metabólica em repouso mais baixa e, por essa razão, não se cansarem tão depressa. A outra peça que examinei deste ‘puzzle’ foi a sobrevivência à fome, algo em que as mulheres levam imensa vantagem. Acho que é daí que deriva a performance de ultrarresistência."
Este cientista não menciona as exigências da gravidez, em tempos comparada com correr uma maratona todos os dias. Será esta a derradeira prova da sua teoria? Sharon Moalem é demasiado científico para chegar a esse ponto. "Basta dizer que a gravidez de um mamífero exige uma resposta biológica e uma adaptação incríveis. No entanto, até termos um macho XY grávido não há como fazer essa comparação e ter certezas absolutas. No entanto, eu diria que ainda mais impressionante do que a capacidade genética feminina para levar uma gravidez a termo é a sua capacidade para ultrapassar a fronteira supercentenária. Não há nada biologicamente mais difícil para um ser humano do que alcançar e ultrapassar os 110 anos."

Moalem é igualmente cuidadoso em não tirar muitas conclusões acerca do coronavírus… por enquanto. "Sim, infelizmente e até à data parece haver mais homens a sucumbir ao Covid-19, [mas] só saberemos se houve efetivamente mais homens infetados alguns anos depois de a pandemia acabar. Posto isto, o MERS, outro tipo de coronavírus com o qual temos mais experiência e mais dados epidemiológicos, mata efetivamente mais homens."
Não se percebe bem como, mas durante milénios a ciência e a sociedade conseguiram ignorar tudo isto. Preferimos o mito do homem forte. "Enquanto médico e cientista, ensinaram-me que os homens são mais fortes", significando não apenas mais musculados, mas mais robustos, em geral. "Demorei 20 anos a desconstruir esse paradigma."
Moalem sabe que vai haver resistência à sua teoria. "Pensei muito nisso enquanto pensava em escrever este livro. É uma ideia perigosa e vai perturbar muita gente. Provavelmente já perturbou. Sempre que há uma mudança de paradigma, encontra-se imensa resistência. Mas é uma lei tão elementar da biologia que ignorá-la reverte em nosso prejuízo, no que diz respeito a aplicações médicas. Foi isso que me deu motivação e coragem para dizer: ‘Sabem, é altura de mudar as coisas.’"

Um dos aspetos em que isto nos tem prejudicado é a prescrição de medicamentos. Estranhamente, diz Moalem, os cientistas preferem usar ratos de laboratório machos para testar fármacos. "Até à data, a investigação pré-clínica não exige a utilização de ratos machos e fêmeas", afirma. É claro que existem estudos com ratos fêmeas, mas os cientistas costumam preferir usar machos por estes serem menos hormonais do que as fêmeas, o que, segundo afirmam, produz dados mais claros. Existe, porém, uma desvantagem, considera Sharon Moalem: os médicos chegaram à conclusão de que as mulheres comunicam mais efeitos secundários do que os homens. Isto não se deve ao facto de serem mais fracas, mas a estarem a ingerir doses excessivas com base nos testes feitos a ratos machos. Os corpos das mulheres retêm os químicos, incluindo o álcool, durante mais tempo e, por isso, os efeitos e os efeitos secundários são intensificados.
Para este cientista, a verdade essencial subjacente à sua tese é que as mulheres são mais bem construídas. A razão pela qual nascem menos bebés do sexo feminino do que do masculino é porque o processo de construção é mais complicado, havendo um número ligeiramente superior de embriões e fetos femininos rejeitados antes do nascimento. "Construir uma mulher é um processo incrivelmente complicado. Tem de correr na perfeição. Se não for assim, está tudo perdido." Moalem acredita que a explicação disto reside nas profundezas das células das mulheres. Os seres humanos costumam ter 23 pares de cromossomas – espirais de DNA portadores de genes – em cada célula.
Um destes pares – os cromossomas do sexo – é diferente nos homens e nas mulheres. Nas mulheres consiste em dois cromossomas ditos X – um da mãe e outro do pai. Nos homens consiste num X da mãe e num Y do pai. A função principal do cromossoma Y é produzir testículos e esperma, sendo relativamente pobre em informação genética comparado com o cromossoma X. Durante anos acreditou-se que um dos dois cromossomas X das mulheres estava efetivamente "mudo". Isto alimentou a mitologia segundo a qual "os homens são mais fortes". Até houve uma saga de romances e uma série de televisão – The XYY Man – que sugeria que ter dois Y tornava um homem mais forte e propenso à criminalidade. É um disparate.

Na verdade, cerca de um quarto dos genes do cromossoma X "mudo" continuam ativos e acessíveis às células humanas. Por conseguinte, uma mulher tem duas possíveis fontes de informação genética para combater as doenças, a fome ou a exaustão. Os homens têm apenas uma. Portanto, na opinião de Moalem, a detenção de dois X é a fonte da superioridade feminina. "Sabemos, agora, por que razão é tão importante: muitos dos genes utilizados para fazer o cérebro estão no cromossoma X. Como tal, muitos dos genes envolvidos na função imunitária estão no X. É como ter 23 volumes de manuais de instruções em casa. No entanto, para os seres humanos o mais importante diz respeito ao cérebro e à imunidade. Sem imunidade não vamos durar muito tempo."
Sharon Moalem é um polímato enérgico. Nasceu em Montreal e trabalha e exerce medicina em Nova Iorque, onde se tornou uma estrela das redes sociais. Em 2007, o seu livro campeão de vendas, Survival of the Sickest, defendeu o argumento de que algumas doenças nos ajudam a viver mais tempo. O seu bestseller seguinte, editado em 2009, foi How Sex Works que apresentava os mais recentes estudos sobre sexualidade e explicava por que razão as pessoas são atraentes para as outras. "Eu sempre fui motivado por perguntas muito simples ou por um conjunto de perguntas que acaba numa única pergunta, para a qual não consigo encontrar uma resposta satisfatória. E se eu receber olhares vazios ou risos, sei que estou atrás de alguma coisa interessante."
É por isso que persegue ideias grandes e ocultas e depois as promove com tanta energia. Moalem tem 43 anos, um ar decidido e um estilo ligeiramente executivo, com o seu fato azul e sapatos brogue castanhos claros. Tem instinto para ir atrás daquilo que escapa aos outros, esquisitice que aponta para uma verdade mais profunda e menos familiar. A resiliência das mulheres, por exemplo, foi enterrada não só pela mitologia, mas também por teorias equivocadas. Ele reparou nisso quando ainda era estudante. "Alguém poderia perguntar: por que razão é que a maioria dos estudos médicos são feitos com homens? E as respostas seriam: ‘Bem, eles são mais fortes; não queremos correr o risco de usar uma mulher que é o sexo mais fraco; poderíamos fazer-lhe mal. Os homens são feitos de um material mais resistente e conseguem aguentar.’ Isto foi-me incutido e aos meus colegas. Mas tudo o que eu via indicava o contrário. Confundimos a ideia de sermos capazes de atirar uma lança mais longe do que uma mulher e de conseguirmos correr mais depressa e pegar em mais coisas pesadas com a força do organismo."
A maior longevidade feminina costumava ser explicada pelo facto de os homens se portarem mal – correrem mais riscos, irem para a guerra, fumarem mais, beberem mais, envolverem-se mais em lutas e por aí adiante. Mas isto não explicava a fraqueza masculina com a qual, claramente, nascemos. "Além dos erros de desenvolvimento que parecem ocorrer mais nos machos, a outra coisa que eu estava sempre a ver era uma vantagem de sobrevivência nas unidades de cuidados intensivos neonatais com crianças muito novas, muito pequenas", diz Moalem. "Quando falava com os enfermeiros, eles revelavam-se poços de sabedoria porque faziam o mesmo trabalho há 30 anos. Queixavam-se que andavam a dizer aquilo aos médicos há imenso tempo. Sempre que vemos um rapaz e uma rapariga em circunstâncias semelhantes, ficamos mais preocupados com os rapazes. Por isso, se estamos perante uma vantagem de sobrevivência, não é uma questão comportamental."
Para as mulheres, existe uma desvantagem em tudo isto. Existe um paradoxo inerente à longevidade das mulheres: embora vivam mais do que os homens, tendem a sofrer mais de doenças ao longo da vida. Isto é intrigante, mas agora, diz Sharon Moalem, talvez o tenhamos resolvido. "Não é que as mulheres adoeçam mais. A questão é que os homens adoecem e morrem." Assim sendo, não é um paradoxo. A resposta é simples – as mulheres não estão a morrer."
Existe um tipo de doença que afeta mais mulheres do que homens. O segundo cromossoma X dá-lhes a vantagem de um sistema imunitário mais eficaz, mas também as torna mais vulneráveis a doenças autoimunes, nas quais o organismo se ataca a si próprio. Estas incluem artrite reumatoide, doença celíaca, doença inflamatória intestinal, entre mais de uma centena de outras. À semelhança do que acontece com o cancro, os homens têm mais probabilidades de morrer devido a estas doenças, mas ao contrário do cancro, as mulheres são mais propensas a serem afetadas.

Portanto, irá o mundo mudar quando as notícias sobre a superioridade genética feminina forem aceites? "Quando um paradigma muda, a sociedade muda em conformidade. No entanto, a resistência com que me deparo quando digo que as mulheres são biologicamente mais fortes do que os homens diz-me que a ideia oposta ainda é a dominante. Há tantas decisões em áreas como o emprego que são afetadas por isso. É como as ultramaratonas. As mulheres são desencorajadas a competirem nestes ultraeventos por serem tão árduos. Achava-se que uma mulher não conseguiria sequer participar. Depois deixaram as mulheres competirem com os homens e depois as mulheres começaram a vencer os homens. Uma mulher não pode vencer uma corrida se não estiver a correr."
Moalem considera que poderá haver uma "reimaginação" daquilo que significa ser forte. "No passado, força significava ser capaz de se defender a si próprio, a sua família, a sua tribo e o seu grupo. Isso dependia de força física. Mas nós evoluímos enquanto sociedade e agora as máquinas e a tecnologia fornecem mais força do que um humano consegue gerar. Existe o risco de surgirem novas formas de preconceito e discriminação contra os homens. Mas essas atitudes não existem na ciência. O subtítulo do livro de Moalem é On the Genetic Superiority of Women. A palavra-chave é "genética". Os genes não tornam uma pessoa "melhor" do que outra, mas apenas diferente. A natureza equipou homens e mulheres para fins diferentes: os primeiros para a força física e as segundas para a resiliência para que, nas palavras de Sharon Moalem, "sobrevivessem tempo suficiente para assegurar a sobrevivência da nossa descendência, ou seja, a sobrevivência de todos nós". Resumindo, estamos todos juntos neste jogo de sobrevivência e somos todos essenciais e iguais.
Créditos: Exclusivo The Sunday Times Magazine/Atlântico Press. Tradução: Erica Cunha e Alves

